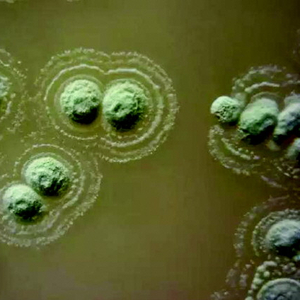

新发现的能够阻止超级细菌生长的细菌。
本报记者 任志方
新的“超级细菌”还会陆续出现
1961年,英国科学家Jevom的研究中,将他发现的耐甲氧西林青霉素金黄色葡萄球菌(MRSA)首次称为“超级细菌”。其发现距今已有50多年的历史,一直头顶“超级杀手”的称号。
近年来,越来越多的超级细菌被陆续发现。2016年,美国政府宣布,在一名女性的尿液中发现“超级细菌”,这种细菌对所有抗生素耐药,就连被视为抗生素“最后一道防线”的多粘菌素也丧失效力。多粘菌素是一种强效的抗生素,传统上被用作对付危险的“超级细菌”的最后手段。
2017年英国卫生部门发出安全警报,称耐药性“超级病菌”耳道假丝酵母菌已在全英55家医院蔓延,当时有200多名病人被发现携带该致命病菌或被感染。
此外,曾经被普遍用来治疗常见的肠道与尿道感染、肺炎、新生儿感染以及淋病的药物,现在对很多人已经不管用了,因为引起上述感染的细菌已对抗生素药物产生很强的抵抗能力。
世卫组织说,感染“超级细菌”患者的死亡率大约是感染不耐药细菌患者的两倍。有专家预测,按照目前的态势,新的超级细菌还会陆续出现,10—20年内,现在所有的抗生素对它们都将失去效力。
去年11月,生物学家在巴西发现数十种新的沙门氏菌菌株,这些菌株对大多数常用的抗生素具有耐药性。巴西圣保罗大学学者费南达·阿尔梅达称:“我们发现,在食物和人体内都有大量对不同抗生素具有耐药性的沙门氏菌菌株,这说明现在巴西因食品感染爆发流行病的风险非常高。”
沙门氏菌在1982年至2013年间曾造成巴西发生集体腹泻和发烧,沙门氏菌90种基因组已被破译。然而阿尔梅达和她的同事发现,过半沙门氏菌菌株已对一种或多种抗生素具有耐药性。
这一分析表明,沙门氏菌后来又迅速发展出40多种基因,能使它对某一种或好几种抗生素免疫。其中部分基因是它们自主获得的,另一些则可能是从其他危险细菌那里“借”来的。
目前,超过一半的巴西沙门氏菌菌株已不受磺胺类药物和链霉毒影响,还有三分之一对四环素和庆大霉素没有反应,7%开始对抗被称为“抗生素最后希望”的头孢菌素的作用。
如何能高效率地获得抗生素抗性
基因突变是产生超级细菌的根本原因。细菌耐药性的产生是临床上广泛应用抗生素的结果,而抗生素的滥用则加速了这一过程。抗生素的滥用使得处于平衡状态的抗菌药物和细菌耐药之间的矛盾被破坏,具有耐药能力的细菌也通过不断的进化与变异,获得针对不同抗菌药物耐药的能力,这种能力在矛盾斗争中不断强化,细菌逐步从单一耐药到多重耐药甚至泛耐药,最终成为耐药超级细菌。
2016年9月,《科学》杂志上刊登了一篇论文,科学家们设计了一种全新的装置,模拟细菌在较大空间尺度、不同抗生素浓度环境下的生存、迁移、变异情况。在这个装置中,大肠杆菌仅用了10天左右的时间,便产生了对抗1000倍于原始致死量的抗药性。
究竟什么样的进化机制,使得细菌能够如此高效率地获得抗生素抗性?
去年10月12日,《科学》杂志发表重磅文章,来自新加坡国立大学医学院和英国格拉斯哥大学的研究人员揭示,当噬菌体感染细菌时,会通过一种新的基因转导的方式,在细菌与细菌之间大规模转移DNA。正是这一过程,大大加速了细菌的进化速度,从而导致和加速细菌抗生素耐药性的出现,以及新的致病菌株出现。
这是迄今为止发现的能够以高频率转移大片段DNA的基因转导机制,也是60年来研究人员首次发现新的遗传转导机制,被称为横向转导。这种高效的基因转移模式,有助于解释细菌的快速进化,比如对多种抗生素耐药的细菌菌株的进化。横向转导的发现,更加证明了基因转导对于微生物进化的驱动影响,也揭开了各种致病耐药细菌高速高效进化的深层机制。
用超级细菌消灭超级细菌
面对难缠的超级细菌,世界各国都在鼓励研究人员加强抗耐药菌药物研究。英国甚至悬赏千万英镑鼓励科学家攻克抗生素耐药性这一重大难题。
去年9月,英国《自然》杂志发表了一项微生物学新发现:科学家报告说,arylomycin一类的天然产物经化学优化后,能够成为对多重耐药革兰氏阴性菌(如大肠杆菌)感染具有强效、广谱抗菌活性的化合物。在此之前50多年,一直没有对革兰氏阴性菌具有抗菌活性的新型抗生素问世。
这项体外实验和小鼠实验的最新研究成果,可以让这类化合物成为一种全新的必需药物,用来对抗全球健康所面临的一大严重威胁。
除了积极研发新型抗生素外,研究人员还另辟蹊径,尝试利用更古老更原始的超级细菌来制伏抗性越来越强的耐药菌,也就是用超级细菌消灭超级细菌。
去年12月,研究人员通过分析长期以来被认为具有药用特性的北爱尔兰土壤发现,它含有一种以前未知的细菌菌株,可有效对抗抗生素耐药的六大超级细菌中的四种,包括MRSA。他们分析的土壤取自北爱尔兰的弗马纳地区,被称为波西米亚高地。这是一片碱性草原,土壤被认为具有治疗功效。
2017年,一支研究小组发现加拿大“铁幕洞”300米深处存在着另一类“超级细菌”,该洞穴系统位于加拿大不列颠哥伦比亚省,这里有大量远古细菌,由于环境偏远封闭,远古细菌一直未受到外界干扰。
这种细菌已经从人类、社会和抗生素药物中分离了400多万年时间,一方面这些远古细菌能够使现代医学一些可用最有效药物完全失去药效。另一方面,它们也将是现代超级细菌的克星,因为它们的抗菌能力是“与生俱来的”。
由于这些细菌所处的深度,它们在洞穴无法获得阳光,令人难以置信的恶劣条件意味着细菌菌群之间经常爆发残酷的战争,它们试图窃取对方的宝贵生存资源。通过菌群之间残酷的地下化学战争,多数细菌进化形成抗菌能力作为“终极武器”。
这些研究结果表明,科学家、历史学家和考古学家都可以为这项任务做出贡献。这个非常现代问题的部分答案可能就在过去的智慧中。
本稿件所含文字、图片和音视频资料,版权均属齐鲁晚报所有,任何媒体、网站或个人未经授权不得转载,违者将依法追究责任。